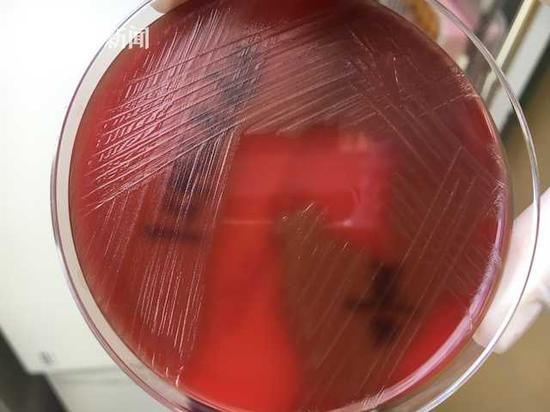

家住在美国俄亥俄州坎顿市(Canton)的女子玛丽近日突遭横祸,她没想到自己和家中小宠物的一些互动竟差点让自己送了命。

5月10日,玛丽刚与丈夫特拉纳度完假返回家中。没过多久,玛丽就感觉身体不适,原本以为自己只是流感,但体温突然骤升又突然下降,她被紧急送到医院治疗。随后她被查出患有严重的败血症,短短几天内她的四肢开始坏死并且陷入危险的昏迷状态。
在玛丽昏迷的10天内,她共接受了8次手术,医生为了挽救她的生命被迫截掉了她坏死的四肢。在接受了80多天的治疗后,玛丽才最终活了下来。

传染病专家科比博士(Margaret Kobe)后来通过血液检查,确认入侵玛丽血管的细菌是犬咬二氧化碳嗜纤维菌(Capnocytophaga),这种细菌通常活在犬科动物或猫科动物的口中。玛丽回忆称,她曾被家中的两只宠物狗舔过自己手臂上的伤口。科比博士表示,出现这样的极端案例十分罕见。
